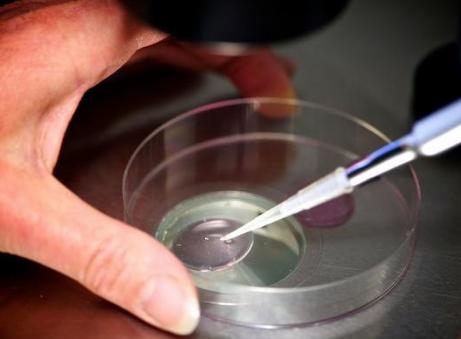
试管移植之后几周去医院做第一次超声检查？

试管移植之后几周去医院做第一次超声检查?
更新时间:2023-04-27
问题描述:
最近我在某医院做了试管移植,身体情况一般,每天都有头晕、头痛、眼睛干涩、乏力等症状,也有反应比较慢、精力不足等情况,现在想知道做完试管移植后几周要做一次超声检查?精选回答:
试管移植可以帮助患者受孕,但是也需要患者进行及时的检查,以确保治疗的有效性。根据临床实践,做完试管移植后应该在4-6周后进行超声检查,以确认胚胎的发育情况。超声检查可以检查胚胎的发育情况,可以发现胚胎的发育不良以及可能存在的其他问题,为下一步的治疗提供重要的参考依据。在检查过程中,医生也会对患者的身体情况进行全面检查,以确保患者正在正常发育,可以正常度过受孕期。患者也可以根据检查结果,积极采取有效措施,保持健康,以最大限度地提高受孕的机会。
以上就是医院招聘网小编为大家整理的《试管移植之后几周去医院做第一次超声检查?》相关信息,希望大家喜欢。
做试管婴儿发生空囊的几率一般有多少? 做完试管移植手术,半夜老是惊醒会有影响吗? 试管婴儿胎停之后还有恢复的可能性吗? 做试管移植手术需要夫妻双方都在现场不? 40岁高龄想要个孩子,领养好还是做试管好? 有高血糖会影响卵巢卵泡发育吗?怎么控制高血糖? 做完鲜胚移植之后吃香蕉要不要紧? 高龄女性怀孕一般会有哪些风险问题?
内容版权声明:本网站部分内容由网上整理转发,如有侵权请联系管理员进行删除.